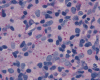

PAS
PAS
GMS
GMS
| A 44 year-old Woman with
Abdominal Pain. May, 2005, Case 505-2. Home Page |
Camtu Truong, M.D. 1, Matthew M. Yeh, M.D., Ph.D.2 Last update: September 1, 2005.
1 Department of Pathology, University of Oklahoma Health Sciences Center, Oklahoma City, Oklahoma and 2 Department of Pathology, University of Washington, Seattle, WA.
Clinical information: The patient was a 44 year-old woman with a diagnosis of HIV-2 about 2 years ago. She presented with the chief complain of severe abdominal pain and profuse diarrhea for one month. There was also diffuse lymphoadenopathy. A colonic endocsopy with biopsy was obtained. The following photos are representative of the biopsy material.
 |
 |
 |
 |
 |
|
| A. | B. | C. | D. | E. | |
 |
|
 |
 |
||
|
F. PAS |
G. PAS |
H. GMS |
I. GMS |
||
Pathology of the case:
On low-magnification, the biopsy appears to be a piece of colonic mucosa without evidence of necrosis, erosion, or ulcer (Panel A). On medium-magnification, the lamina contains some vaguely formed collections of large cells (Ú in Panel B). On high-magnification, there are many large, round cells with eccentric nuclei. These are macrophages in clusters that are consistent with granulomas. Many small, grayish to basophilic, vesicle-like structures are present in the cytoplasm (Panel in C). In other areas, these large, round cells do not really form small clusters and are admixed with lymphocytes (Panel D). Again, many small, grayish vesicle-like structures are present in these cells. A grayish to basophilic core is present and is surrounded by halo (Ú in Panel E). These structures are most suggestive of microorganisms particularly fungus. On periodic acid Schiff (PAS), these vesicles appear bright purple-red (Panel F and G). The basophilic core is also strongly positive for PAS stain (Panel G). These microorganisms appear dark with Gomori methamine silver stain (Panel H and I).
Comment: The pathologic changes in this case are morphologically consistent with histoplasmosis. The patient is immunocomrpomised (HIV-2 positive). Typical to these cases are poorly formed granuloma as illustrated in this case.
| DIAGNOSIS: Histoplasmosis (in an HIV seropositive patient) of colon. |
Discussion: General Information Clinical Disseminated Pathology Diagnosis GI Histoplastmosis
General Information
Histoplasma capsulatum, a dimorphic slow-growing fungus, is found worldwide in regions of moderate climate and high humidity. The mycelial form can be found in nature and also in laboratory culture. In tissue, they occur only as yeast form. In the United States, it is highly endemic in the Ohio and Mississippi river valleys. The sporulation of H. capsulatum in soil is accelerated by bird and bat droppings due to the added nutrients of such excrements. Hence, cave workers, farmers, and those involved in activities that disrupt the soil or old buildings are at greatest exposure risk. A majority of patients have an asymptomatic and self-limiting infection 1, 2. However, severe to life threatening infection can occur in immunocompromised patients particularly those with compromised cellular mediated immunity, patients that have been exposed to a very high volume of infecting spores, and patients with underlying chronic diseases 1, 2, 3, 4.
The organism gains human entry through inhalation of the aerosolized microcondia (spores) produced by the mycelial (yeast) form of H. capsulatum. Once localized in the alveoli, the microndia transform into the mycelial form. The yeasts are then ingested by pulmonary macrophages within which the organisms multiply and migrate to the pulmonary hilar and mediastinal lymph nodes, and subsequently hematogenously spread to various other organs. Cellular immunity develops approximately 10 days to three weeks after exposure in the immunocompetent host. The infection is then controlled by the macrophages’ fungicidal properties 3, 4. Conversely, in the immunocompromised host with impaired cellular immunity, the infection can become progressively disseminated, rendering a poor prognosis 1. Chronic pneumonia can occur in immunocompetent patients who has been exposed to a large volume of infecting spores 3, 4. Reinfection and reactivation of quiescent infection, precipitated by periods of immunosuppression, can also occur years after exposure 5.
In the majority of immunocompetent hosts, a low level of exposure to H. capsulatum typically results in asymptomatic infection. Although most cases are sporadic, major community outbreaks have occurred 6, 7. Following a more intense, heavy exposure, acute pulmonary histoplasmosis can be seen in 10 to 50% 8. Common symptoms include high fever, chills, headache, malaise, myalgia, pleuritic chest pain, cough, and dyspnea. The degree of severity correlates with the number of microcondia inhaled 3, 4, 5, 7, 8. Chest radiographs typically do not show significant abnormalities. The most frequent abnormal feature is diffuse reticulonodular pulmonary infiltrates. Occasionally, hilar and mediastinal lymphadenopathy can be seen 7.
In patients with preexisting abnormal lung architecture such as emphysema, chronic pulmonary hisoplasmosis can occur. Common symptoms include malaise, fever, night sweats, weight loss, chronic productive cough, and hemoptysis. Chest radiographs may show fibrotic apical infiltrates with cavitation 1, 2, 9.
Disseminated histoplasmosis is a rare manifestation of H. capsulatum infection, occurring mostly in immunocompromised hosts, especially in those infected with HIV-1 with a CD4 lymphocyte count under 150 – 200 x 106 per L 9. Severity of the disease varies with the degree of immunodeficiency 4. In AIDS patients, infants and those with severe immunosuppression, the clinical course is often acute and rapidly fatal. Obtundation, respiratory distress, shock, hepatic and renal failure and coagulopathy are the common clinical presentation 10.
In middle-aged to older immunocompetent adults, the clinical course of disseminated histoplasmosis is usually chronic and progressive. The majority of the patients present with fatigue, respiratory symptoms, fever, night sweats, weight loss, lymphadenopathy as well as hepatosplenomegaly. Some patients can present with skin and mucosal lesions10.
Organs commonly affected are the adrenal gland, central nervous system and the heart. Abdominal CT or ultrasound demonstrates adrenal gland involvement in more than 50% of patients with disseminated histoplasmosis. The same finding has also been observed in those who die of histoplasmosis. Central nervous system involvement occurs in 5 to 10% of patients with disseminated histoplasmosis with subacute or chronic meningitis being the most common manifestation. Endocarditis occurs in approximately 4% of cases of disseminated histoplasmosis 3, 4.
Other uncommon sites of involvement include the bone, joints, and kidneys. Esophagus, gallbladder, cystic duct, common bile duct, peritoneum, omentum, urinary bladder, penis, prostate, testis, epididymis, vagina, ovary and breast are among the rare sites of dissemination 4.
In immunocomprised patients that have defective cellular immunity, granuloma formation may be rather indistinct as illustrated in our case. The yeast form of Histoplasma capsulatum is found in tissue and they are usually under 5 mm in diameter and appear as ovoid yeasts. The lung is the most affected organ. Granuloma formation, typically multiple, with extensive caseous necrosis and a variable amount of calcifications are the typical pathologic changes in the lung. These granulomas are often demarcted from the surrounding tissue by a fibrous wall. Granulomas in the lung can get quite calcified with time. The pulmonary nodules can also enlarge slowly to give a wrongful clinical impression of neoplasm, the so-called histoplasmoma. The living yeast in tissue, often occur in clusters, has a basophilic center and a translucent halo that represents the capsule. They are often engulfed by histiocytes as illustrated in this case. Dead organisms appear eosinophilic and cannot be detected easily in granuloma by hematoxylinj-eosin stain. The microorganism is numerous and can be identified on routine hematoxylin-eosin stain with astute observation and high index of suspicion. Typically, there are numerous yeasts and they are present even in heavily calcified nodules or granulomas.
H. capsulatum, like many other fungal organisms, are well demonstrated by periodic acid Schiff (PAS) stain, Gomori’s methamine silver (GMS) stain, and other appropriate stains in tissue. Although the size and shape can suggest Candida species, there is no pseudohyphae formation in H. capsulatum which allows the distinction. They also lack the paired dense capsular thickening as in Pneuocystis carinii. Coccidiodes immitis form large endospores which allow separation from H. capsulatum. [Click here to see a picture of C. immitis with GMS stain]
Laboratory tests used in the diagnosis of histoplasmosis include fungal cultures, fungal stains, serologic tests for antibodies, and antigen detection. Culture is still the gold standard in diagnosis. Each test has its own advantages and limitations. Cultures are positive in approximately 85% of chronic pulmonary or disseminated histoplasmosis although incubation requires 2 to 4 weeks 12. Fungal stains can allow rapid diagnosis but staining artifacts and minimal experience with the staining characteristics of fungal organisms can lead to a false diagnosis 3, 4. Serologic tests for antibodies are rapid and sensitive. However, in immunocompromised patients, the test can yield false-negative results during the 2 to 6 week post-exposure period while the antibodies are still developing. Additionally, false positive results can occur in those previously infected with other fungal organisms 12, 13. Antigen detection can give rapid results in disseminated cases. The sensitivity is lower with serum than urine. Both urine and serum should be tested in order to achieve optimal diagnostic yield 12.
Histoplasmosis of the gastrointestinal tract
Although autopsy findings have identified the presence of Histoplasma capsulatum in the gastrointestinal tract of 70-90% of patients with progressive disseminated histoplasmosis 10, 14, 15, H. capsulatum is uncommonly recognized as the causative agent in gastrointestinal disease. This organism is considered to be the etiologic agent in only 3-12% 16,17 of patients with gastrointestinal clinical symptoms perhaps due to the non-specific clinical presentation of gastrointestinal histoplasmosis. The most common symptoms include abdominal pain, fever, diarrhea and weight loss. Intestinal obstruction, gastrointestinal bleeding and perforation are less frequently reported 16. Common clinical manifestations include ulcers, hemorrhage, nodules and masses 18 which can mimic inflammatory bowel disease or malignant process making the diagnosis challenging 19. Gastrointestinal involvement in disseminated histoplasmosis can involve any segment of the gastrointestinal tract containing lymphoid tissue. Terminal ileum, therefore, is the most frequent site of involvement in the GI tract due to the abundant amount of lymphoid tissue 20.
Reference:
Conces DJ Jr. Histoplasmosis. Semin Roentgenol 1996 31:14-27.
Gurney JW, Conces DJ. Pulmonary histoplasmosis. Radiology 1996 199-297-306.
Kurowski R, Ostapchuk M. Overview of histoplasmosis. Am Fam Physician 2002 66:2247-52.
Wheat LJ, Kauffman CA. Histoplasmosis. Infect Dis Clin N Am 2003 17:1-19, vii.
Goodwin RA, Loyd JE, Des Prez RM. Histoplasmosis in normal hosts. Medicine (Baltimore) 1981 60:231-66.
Wheat LJ, Slama TG, Eitzen HE, Kohler RB, French ML, Biesecker JL. A large urban outbreak of histoplasmosis: clinical features. Ann Intern Med 1981 94:331-7.
Brodsky AL, Gregg MB, Loewenstein MS, Kaufman L, Mallison GF. Outbreak of histoplasmosis associated with the 1970 Earth Day activities. Am J Med 1973 54:333-42.
Rubin H, Furcolow ML, Yates JL, Brasher JL. The course and prognosis of histoplasmosis. Am J Med 1959 27:278-88.
Bradsher RW. Histoplasmosis and blastomycosis. Clin Infect Dis 1996 229suppl 2):S102-11.
Goodwin RA Jr, Shapiro JL, Thurman GH, Thurman SS, Des Prez RM. Disseminated histoplasmosis:clinical and pathologic correlations. Medicine (Baltimore) 1980 59:1-33.
Sathapatayavongs B, Batteiger BE, Wheat J, Slama TG, Wass JL. Clinical and laboratory features of disseminated histoplasmosis during two large urban outbreaks. Medicine (Baltimore) 1983 62:263-70.
Williams B, Fojtasek M, Connolly-Stringfield P, Wheat J. Diagnosis of histoplasmosis by antigen detection during an outbreak in Indianapolis, Indiana. Arch Pathol Lab Med 1994 118:1205-8.
Wheat J, Wheat H, Connolly P, Kleiman M, Supparatpinyo K, Nelson K, Bradsher R, Restrepo A. Cross-reactivity in Histoplasma capsulatum variety capsulatum antigen assays of urine samples from patients with endemic mycoses. Clin Infect Dis 1997 24:1169-71.
Goodwin RA Jr, Des Prez RM. State of the art:Histoplasmosis. Am Rev Respir Dis 1978;117:929-56.
Haggerty CM, Britton MC, Dorman JM, Marzoni FA Jr. Gastrointestinal histoplasmosis in suspected acquired immunodeficiency syndrome. West J Med 1985;143:244-6.
Suh KN, Anekthananon T, Mariuz PR. Gastrointestinal histoplasmosis in patients with AIDS: Case report and review. Clin Infect Dis 2001; 32:483-91.
Wheat LJ, Connolly-Stringfield PA, Baker RL, Curfman MF, Eads ME, Israel KS, Norris SA, Webb DH, Zeckel ML. disseminated histoplasmosis in the acquired immune deficiency syndrome: Clinical findings, diagnosis and treatment, and review of the literature. Medicine (Baltimore) 1990; 69:361-74.
Lamps LW, Molina CP, West AB, Haggitt RC, Scott MA. The pathologic spectrum of gastrointestinal and hepatic histoplasmosis. Am J Clin Pathol 2000; 113:64-72.
Kahi CJ, Wheat LJ, Allen SD, Sarosi GA. Gastrointestinal histoplasmosis. Am J Gastoenterol. 2005; 100:220-31.
Cappell MS, Mandell W, Grimes MM, Neu HC. Gastrointestinal histoplasmosis. Dig Dis Sci 1988; 33:353-60.